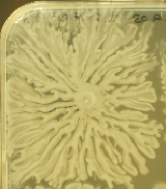
Refer to caption

Reaction-diffusion model for pattern formation in swarming colonies with slime.
Abstract
A new experimental colonial pattern and pattern transition observed in MG1655 swarming cells grown on semi-solid agar are described. We present a reaction-diffusion model that, taking into account the slime generated by these cells and its influence on the bacterial differentiation and motion, reproduces the pattern and successfully predicts the observed changes when the colonial collective motility is limited. In spite of having small non-hyperflagellated swarming cells, under these experimental conditions E. coli MG1655 can very rapidly colonize a surface, with a low branching rate, thanks to a strong fluid production and a local incremented density of motile, lubricating cells.
pacs:
87.18.Hf 87.18.Bb 87.18.Ed 87.80.VtI Introduction
The macroscopic pattern exhibited by a bacterial colony and its dependence on certain environmental parameters can give us some clues about the coordinated colonization strategy followed by the community of cells. The biological interest in this interdisciplinary area is in pointing out under controlled laboratory conditions the cooperative mechanisms (intercellular interactions, motility and communications) that these bacteria, which are traditionally considered as solitary life forms, may have developed to adapt to changing environments. It is an extremely fertile and interesting area for close collaboration between physicists and biologists because it helps both to understand the transition from individual (uni-cellular, a bacteria) to collective (multi-cellular, a colony) behavior Shapiro3 .
Bacterial colony pattern formation on semi-solid agar surfaces has been studied extensively by microbiologists and physicists Shapiro3 ; Viseck ; Harshey ; serratia ; proteus ; Burkart ; phys ; Kearns . Through these works undertaken with colonies arising from different species and strains of bacteria, the following common features have been described: Bacteria can swim in liquid medium without difficulty but in environments with adverse conditions for the swimming motility, they need to develop mechanisms to become more motile. On semi-solid agar medium, where the viscosity is high and the motility of short swimmer cells very low, some may differentiate into very elongated, multinucleated and profusely flagellated swarm cells that can move easier Harshey . The initiation of swarm differentiation seems to be strictly correlated with physico-chemical factors such as surface contact and quorum sensing response (cell density sensing mechanism) serratia . Swarming cells have the ability to extract water from the agar and produce a lubrication fluid (slime). The flagellum driven motility of swarmer cells together with the extracellular slime helps to overcome the surface friction Harshey . After some time migrating swarmer cells have been observed to cease movement, septate and produce groups of swimmer cells (de-differentiation process) proteus . The chemotaxis system is essential for swarming motility in E. coli Burkart . With the chemotaxis mechanism bacteria can orient their motion in response to a gradient (positive or negative) of a certain chemical field (a nutrient or a field produced by the bacterial cells such as chemical signals or a pH change) phys . Based on these experimental observations great effort has been devoted to model the cooperative behavior of a cell community Bjacob0 ; Matsu2 ; Kawasaki ; Golding ; Bjacob .
Here we describe the new pattern and pattern transitions observed in a swarming colony of E. coli MG1655 blatner , a laboratory domesticated wild type strain that produces a lubricating fluid or slime: when the colonial motility is limited this colony expands irregularly with few relatively thick, dense, branches and very rare secondary branches, whereas for conditions of improved colonial motility the pattern is compact and round with structures of higher cell densities. To study the coordinated, self-organized, colonization scheme of this colony and based on experimental microscopic observations, we will define a mathematical model of the cooperative behavior of this colony which is able to predict the pattern transitions when certain control parameters are changed.
This work is organized as follows: in Section II we will introduce the experimental results and their implications for the non-expert reader. Then in Section III, our hypothesis for the collective dynamics will be explained, followed by a mathematical formulation. Results of the computer simulation in comparisons with experiments will be posed and discussed in Section IV. The summary and conclusions are given in Section V.
II Experimental observations
The development of an E. coli MG1655 colony on a semi-solid surface ( βDifcoβ Agar) under certain nutritional (1 βDifcoβ Tryptone, 0.5 βDifcoβ yeast extract, 0.5 NaCl and D-(+)-glucose) and environmental (at C and on average relative humidity) conditions has been studied in detail with round and square laboratory plates of and cm respectively. We inoculated a liquid drop of stationary phase bacteria cultivated overnight (in LB, GG , at C). The following experimental observations were made:
-
β’
The colony expands on the surface in a compact and round shape with few (typically 6 to 8) wide branches. The colonization of the plate takes place very rapidly: at C a plate of 9 cm diameter is colonized in roughly one day, see Fig.Β 1(a).
-
β’
It was observed that the fronts of two colonies inoculated on the same plate never merge unless they meet tangentially. Branches do not simply grow radially from their inoculation point, but avoid this intercolonial demarcation region, see Fig.Β 1(b).
-
β’
The term βswarmingβ is used in the literature to describe the active, flagellar-dependent surface motility of bacteria Harshey . To confirm the relevance of flagella in the mechanisms of surface translocation of this colony we have constructed by P1 transduction miller a flagellar-defective mutant, MG1655 flhD::Kan pruss . The flhDC operon encodes a key master regulator of the hierarchical system controlling the synthesis of the bacterial flagellum in E. coli fla- . Having this operon inactivated the strain MG1655 flhD::Kan can thus not synthesize the bacterial flagella. The wild type and the flagellar-defective mutant were inoculated simultaneously. After one day the mutant had initiated expansion over the surface, due to the combined influence of the expansive forces of bacterial growth (population pressure) and the fluid production. But, in contrast with the wild type MG1655, it failed to continue the rapid surface colonization, see Fig. 1(c). The slow passive form of surface translocation displayed by the mutant is called βspreadingβ Matsuyama . The same pattern was also observed when the flagellar-defective mutant was inoculated alone on a plate and for lower agar concentration (data not shown). Notice also the existence of a clear asymmetric intercolonial demarcation region which has been avoided by the fast expanding wild type colony MG1655. This experiment shows thus that flagellar motility is essential for the surface motility of MG1655 and that we are dealing with an active process of flagellar-dependent swarming motility that is able to avoid a region.
-
β’
The macroscopic characteristics of the experimental patterns are extremely sensitive to humidity which in turn limits the fluid production. When the fluid production is high the pattern is almost compact with circular envelope and has few wide branches with cells deposits and channels structures within. Whereas when the fluid production is limited the colony expands irregularly, with long, relatively thick branches with high cell densities (see Fig.Β 1(d)), very few secondary branches and greater gaps (see Fig.Β 5(b)(d) and (f)).
- β’
-
β’
Along the edge in contact with the slime, one can observe a thin layer of quiescent cells apparently packed in an ordered way. See the lighter line of packed swarmer cells in Fig.Β 2(b), pushed by the turbulent collective motion of groups of swarmer cells in the interior region.
-
β’
In this swarming pattern we found, both in the center and the periphery of the pattern, mononucleated active cells, see Fig.Β 3(a), from to m and also with 4 to 6 flagella, see Fig.Β 3(b). The swimmer cells of E. coli MG1655 found in other patterns with interstitial submerging are roughly m long with 4 to 6 flagella (data not shown). Therefore, under these experimental conditions the swarmer cells of E. coli MG1655 do not seem to undergo a significant change in their cellular characteristics for surface translocation.
| (a) | (b) |
![]() |
![]() |
| (c) | (d) |
![]() |
![]() |
| (a) | (b) |
|---|---|
![]() |
![]() |
| (a) | (b) |
|---|---|
![]() |
![]() |
In order to choose an appropriate model certain features must be emphasized from the experimental observations: In spite of the small, non-hyperflagellated swarming cells, the colony expands very rapidly on the agar showing a strong sensitivity to the surface humidity conditions, we therefore conclude that the lubricating fluid is relevant for the successful expansion of the colony. Furthermore, we believe that the channel-like three dimensional structures are accumulations of bacteria in regions with higher concentration of fluid. As for the intercolonial demarcation region, our hypothesis is that the motion of motile cells is driven by negative chemotaxis avoiding the regions with high concentrations of cells and the substances produced by them. Notice in particular the wide intercolonial demarcation zone in Fig. 1(c). Thus despite the fact that the mutant colony continues to grow (notice the long bacterial filament) which indicates the presence of nutrient in this zone, the swarming wild type colony avoids this region. This suggests that the demarcation zone cannot solely be due to nutrient depletion and there must be some chemotaxis in response to chemical signaling, nutrient level, pH variations, etc.
There are a few other reported examples of colonial pattern formation in the literature, most of them imply the splitting formation of tips and branches but lead to different patterns since the mechanisms of advance and self-organization are also different. We propose to describe this dynamical system by means of a reaction-diffusion system, a standard tool in the field of bacterial colony pattern formation, including well known and widely used features such as lubrication and chemotaxis. The collective diffusion term of the colony must account for the new self-organization mechanisms observed in our experiments: we have seen that an increased density of cells and slime in the tips of the colony helps the colony to advance, being less sensitive to local irregularities and showing thus, in conditions of adverse motility, a poorly branched pattern.
III Reaction-diffusion Modeling
Previous studies on pattern formation of other lubricating bacteria such as P. dendritiformis var. dendron have confirmed that reaction-diffusion models with a lubricating fluid and chemotactic motion can successfully describe the development of branching structures Bjacob . However, when the colonial motility is decreased these models predict a pattern transition from a compact to a highly ramified pattern with thin branches, which is different from the one observed here.
We will next construct a mathematical model of the reaction-diffusion type, to describe our experimental observations. The cells in the colony can be in a normal static phase or in a differentiated motile state where the cells produce liquid and use their flagella to move. Let be the nutrient consumed by cells in their reproduction, see Eq. (3). We include the fluid substance that is excreted at a rate by motile cells and disappears with time at a rate (being reabsorbed into the agar medium or consumed or degraded by the cells), see Eq. (4). The initial condition is the circular inoculum (with radius ) of a drop of liquid with bacteria in the static state in a plate with nutrient . When the concentration of fluid is sufficiently high, greater than a threshold , these static cells reproduce at a rate into more static cells (in our model their reproduction rate is increased in liquid media), see Eq. (2). When the fluid level is too low, i.e. drops below the critical value , and bacteria are in contact with the surface the swarming behavior is triggered: the new cells are motile cells that are able to produce fluid and move, see Eq. (1). With time, motile cells return to the static state at a rate . The diffusion term in Eq. (1) can be expressed as with a flux of motile cells of density and with velocity proportional to , and the gradient of . This velocity represents the fact that motile cells move faster for higher concentrations of motile cells and lubrication fluid , and that the direction of their motion is actively defined by negative chemotaxis moving towards regions of lower motile cell densities and substances produced by them (this negative gradient term could alternatively describe a population pressure in the case of passive translocation). Let be the diffusion parameter of motile cells. The nutrient and fluid fields also diffuse with diffusion constants and respectively. To introduce the local irregularities of the agar we include a local random viscosity term (with a random number of uniform distribution in the interval ) which is constant in time and affects the nutrient diffusion. Our adimensional model reads:
| (1) |
| (2) |
| (3) |
| (4) |
where is the Heaviside step function (other thresholding functions lead to similar results). On swarming experiments a lag phase is always observed after inoculation when bacteria proliferate by cell division at the central spot without any migration. Once the colony has reached some threshold, the swarming process starts, i.e. rapid surface migration is preceded by a cell density-dependent lag period Kearns . The thresholding condition of our model allows us to describe the biological colonial switch between the swimming and swarming state and this aforementioned initial time lag between inoculation and colony spreading.
We have solved this system numerically using a finite difference scheme and an alternating direction technique for the diffusion term. We integrate inside a circular region of radius and set the initial conditions to , , and with and a random number of uniform distribution in the interval . We fix and and let other parameters vary depending on the experiment.
If we set , and we reproduce the experimental pattern. Figures 4 (a) and (c) display the local bacterial density at a certain time for one and two inoculi respectively. The color coding ranges between white for zero density and black for values equal to or higher than . The inner black structures correspond to regions where temporary high concentrations of fluid led to higher reproduction rates and an increment in the static bacterial density. The demarcation region induced by the gradient of the diffusion term can also be distinguished. For the study case (a), we show the local density of fluid at the same given time, see Fig.Β 4 (b). This fluid will disappear with time (it is reabsorbed into the agar or used by the bacteria behind the front).
| (a) |
![]() |
| (b) | (c) |
|---|---|
![]() |
![]() |
IV Numerical results and experimental validation
The model predicts a pattern transition from compact to branched growth as the colony motility is limitted due to a reduction in any of the factors in the collective diffusion term in Eq. (1): or . For instance if the reproduction rate (), the nutrient content () or the possibility to produce slime using water from the agar () are decreased separately the pattern becomes less compact and with an irregular envelope, with relatively thick branches and very rare secondary branches. These numerical results are shown in Fig.Β 5(a),(c),(e) and compared with experimental results where the collective motility is reduced by lowering the temperature (b), the glucose content (d) or the surface humidity (f) respectively. Experimentally the most critical parameter was the humidity: variations of only of the surface humidity had a significant impact on the emerging patterns.
| (a) | (b) |
![]() |
![]() |
| (c) | (d) |
![]() |
![]() |
| (e) | (f) |
![]() |
![]() |
Although the simple pattern analogy is not sufficient to conclude that the model is correct, predicting the behavior when several control parameters are changed is a good tool to validate it. Under the circumstances reported here the parameter that had the strongest impact on the emerging pattern was indeed the humidity. But under different experimental conditions other factors, such as local cell densities and quorum sensing or type and quantity of nutrient supply required for the flagellar synthesis and activation, may be considered as essential.
V Conclusions
Branching is due to the sensitivity of the system to local irregularities whose small perturbing effect is enlarged due to the non-linearity of the diffusion term describing the cooperative spreading of the colony. Branching patterns have also been seen in other bacteria such as B. subtilis, Matshushita , and in P. dendritiformis var. dendron (genera Paenibacillus of B. subtilis), Bjacob . In these colonies, when the motility of the colony is strongly limited, the advancing front is extremely sensitive to local irregularities and shows very frequent tip splitting leading to very ramified, thin branches. In some cases (like the so-called Dense Branching Morphology) the distribution of branch lengths is even exponential, suggesting that the tip-splitting of branches takes place at random Matshushita .
In our study case when the motility is reduced, the density of motile lubricating cells in the advancing front is incremented, the fluid level increases also and the advancing branches are thick, with low branching rate. This mechanism of response of the colony to adverse conditions has been implemented mathematically as follows: a thresholding condition on the fluid level launches the production of lubricating swarming cells V and the reproduction rate is increased in fluid rich regions. Since the collective colonial motility expressed by the diffusion term shows a strong dependence on the density of motile cells , the very dense branches are less sensitive to local irregularities and show thus a lower branching rate.
Studies such as this one are aimed at understanding the principles underlying self-organized pattern formation processes and establishing a systematic correspondence between the observed macroscopic colonial patterns and the putative microscopic collective physics. The new biological pattern has indeed given us some hints about the underlying collective physical principles or colonial strategy.
This strategy, or part of it, may be common to other bacterial patterns. For instance branching patterns have been reported recently on a colony of B. subtilis where potassium ions were shown to increase the production of lubricating fluid with surfactin and thus increment the motility substantially without formation of flagella (not swarming)Kinsinger . When the motility is reduced due to a low fluid production the colony shows also thick branches with relatively low branching rate. A fluid preceding each dendritic finger of growth can be seen. From analysis of this information alone, we conjecture that a similar mechanism may take place in this case: under adverse conditions the production of lubricating cells would be increased, reproduction may also be more effective in fluid rich regions and in turn these branches would have higher density showing again a low sensitivity to local irregularities and low branching rate. The population pressure would also induce here a negative gradient term.
Swarming in E. coli has been previously reported on other strains that swarm due to a differentiation from the swimming state to a swarming-adapted strongly hyperflagellated, multinucleated state HarsehyColi . This present work reports on the swarming ability of another E. coli strain, the wild type MG1655, that shows a greater variety of patterns. Instead of cell hyperflagellation, the strategy chosen for colonization is a strong fluid production and incremented density of motile cells, the result is a fast advancing colony with low branching rate. Since E. coli is a genetically well characterized organism, the experiments reported here can be used for further studies of the genetic expression associated to the collective, self-organized, swarming pattern formation process.
VI Acknowledgments
We thank L. VΓ‘zquez, A. Giaquinta and J. Shapiro for support and careful reading of the manuscript. We are grateful to Birgit M. PrΓΌΓΒ for providing an E. coli strain with the flhD::Kan allele and to Mary Berlyn (E.coli Genetic Stock Center) for suppling the E. coli MG1655 (#CGSC6300) strain. Special thanks go to J.-A. RodrΓguez-Manfredi and F. Camps-MartΓnez for their invaluable assistance with images and videos. The work of M.-P. Zorzano, J.-M. GΓ³mez-GΓ³mez and M.-T. Cuevas is supported by a INTA fellowship for training in Astrobiology.
References
- (1) J. A. Shapiro and M. Dworkin editors, Bacteria as Multicellular Organisms. (Oxford University Press, New York, USA, 1997).
- (2) T. Vicsek, Fluctuations and scaling in biology (Oxford University Press 2001).
- (3) R. M. Harshey, Annual Review of Microbiology 57, 249-73 (2003).
- (4) L. Eberl, S. Molin and M. Givskov, Journal of Bacteriology 181, 1703-1712 (1999).
- (5) S.E. Esipov and J.A. Shapiro, Journal of Mathematical Biology 36, 249-268 (1998).
- (6) M. Burkart, A. Toguchi and R.M. Harshey, Proceedings of the National Academy of Sciences USA 95, 2568-2573 (1998).
- (7) H. Berg, Physics Today 53 (1), 24-29 (2000).
- (8) D. B. Kearns and R. Losick, Molecular Microbiology 49 (3), 581-590 (2003).
- (9) E. Ben-Jacob, I. Cohen, O. Shochet, A. Tenenbaum, A. CzirΓ³k and T. Vicsek, Physical Review Letters 75 (15), 2899-2902 (1995).
- (10) M. Matsushita, J. Wakita, H. Itoh, I. Rafols, T. Matsuyama, H. Sakaguchi and M. Mimura, Physica A 71, 185-207, (1998).
- (11) K. Kawasaki, A. Mochizuki, M. Matsushita, T. Umeda, N. Shigesada, Journal of Theoretical Biology 188, 177-185 (1997).
- (12) I. Golding, Y. Kozlovsky, I. Cohen and E. Ben-Jacob, Physica A 260 (3-4), 510-554 (1998).
- (13) Y. Kozlovsky, I. Cohen, I. Golding and E. Ben-Jacob, Physical Review E 59, 7025-7035 (1999).
- (14) F.R. Blattner et al., Science 277, 1453-1462 (1997).
- (15) J.-M. GΓ³mez-GΓ³mez, F. Baquero and J. BlΓ‘zquez, Journal of Bacteriology 178, 3331-3334 (1996).
- (16) J. H. Miller, A short course in bacterial genetics. (Cold Spring Harbor Laboratory Press, Cold Spring Harbor, N.Y. 1992).
- (17) B. M. PrΓΌΓ, J. W. Campbell, T. K. Van Dyk, C. Zhu, Y. Kogan and P. Matsumura. J. Bacteriol. 185, 534-543 (2003)
- (18) S. Kalir, J. McClure, K. Pabbaraju, C. Southward, M. Ronen, S. Leibler, M.G. Surette, U. Alon, Science, 292, 2080-2083 (2001)
- (19) T. Matsuyama, A. Bashin and R. M. Harshey, Journal of Bacteriology, 177, 987-991 (1995).
- (20) J. Wakita, I. RΓ‘fols, H. Itoh, T. Matsuyama and M. Matsushita, Journal of the Physical Society of Japan 67 (10), 3630-3636 (1998).
- (21) R. M. Harshey and T. Matsuyama, Proceedings of the Nationall. Academy of Sciences 91, 8631-8635 (1994).
- (22) R. F. Kinsinger, M. C. Shirk and R. Fall. Journal of Bacteriology, 185 (18), 5627-5631. (2003).